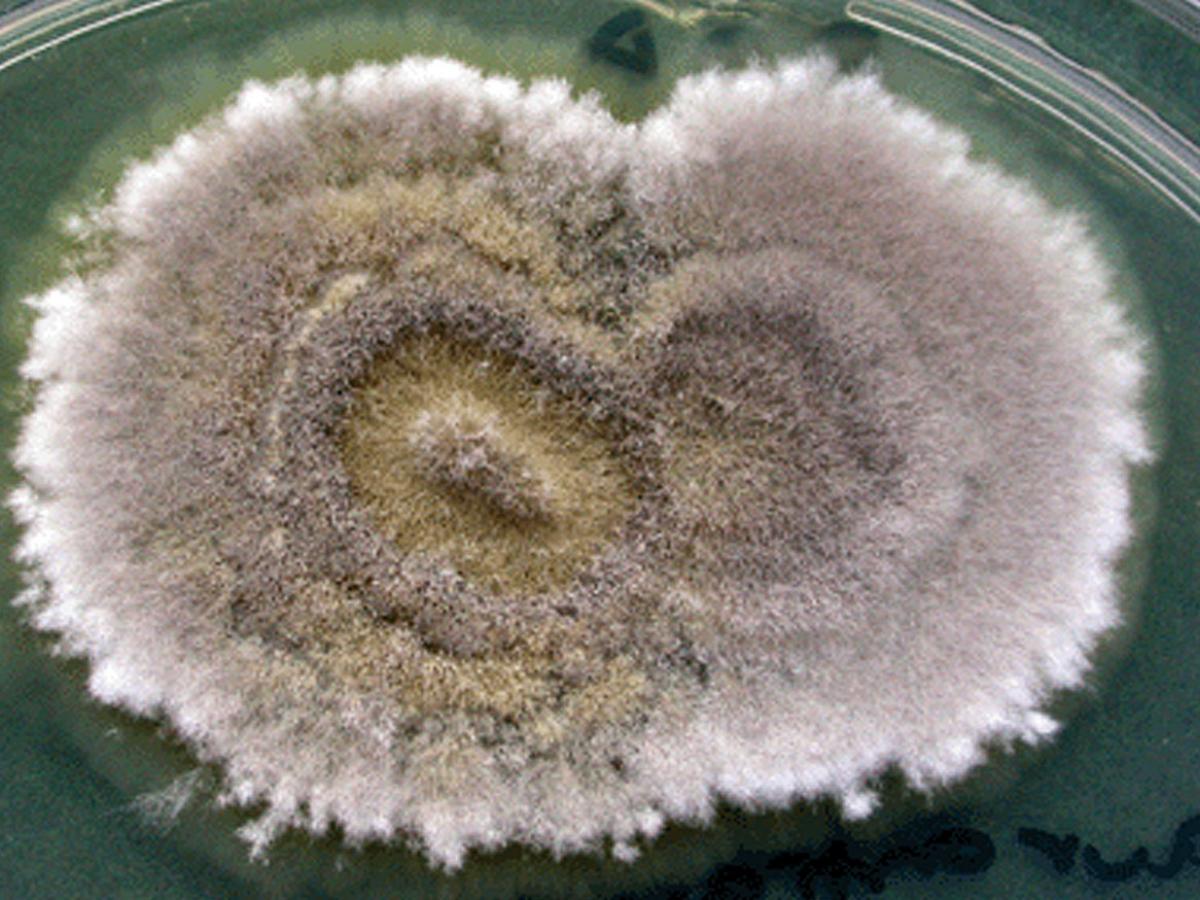
Culture
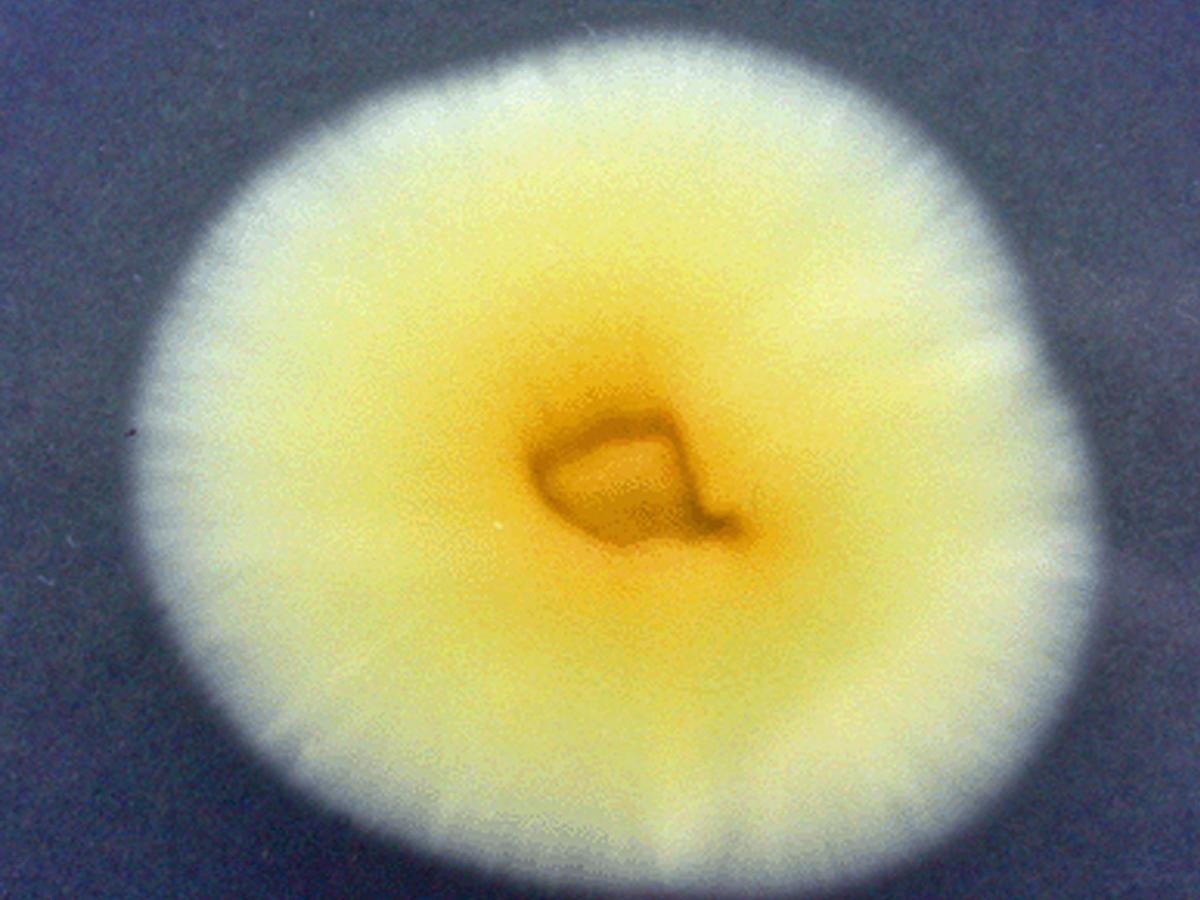
Culture

Status message
Correct! Excellent, you have really done well. Please find additional information below.
Unknown 30 = Scedosporium aurantiacum
Culture: Colonies are fast growing, greyish-white and suede-like to downy. All isolates produce a light yellow diffusible pigment on PDA after a few days incubation.

Microscopy: Conidiogenous cells and conidia are similar in shape and size to S. apiospermum, and the two can best be distinguished by genetic analysis. Conidiogenous cells arising from undifferentiated hyphae are cylindrical to slightly flask-shaped, producing slimy heads of one-celled , smooth-walled, subhyaline, obovoid or sub-cylindrical conidia. Erect synnemata (a Graphium synanamorph) may be present in some isolates, but the teleomorph is unknown. Optimum temperature for growth 37-40C, max 45C.


Comment: S. apiospermum and S. aurantiacum appear to be common soil fungi capable of causing a spectrum of diseases similar in terms of variety and severity to those caused by Aspergillus species collectively referred to as Scedosporiosis (Pseudallescheriasis). The vast majority of infections are mycetomas, the remainder include infections of the eye, ear, central nervous system, internal organs and more commonly the lungs.
About Scedosporium Back to virtual assessment